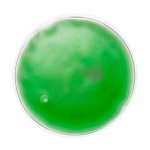

okład rozgrzewający AP781012
SPECYFIKACJA
| Numer katalogowy: | AP781012 |
| Kolor: | czerwony, niebieski, zielony, fuksji, biały, żółty |
| Materiał: | Plastik |
| Wymiary: | ø100×10 mm |
| Cena od: | 4.33 zł |
Opis
Transparentny, wielokrotnego użytku okład rozgrewający z kolorowym żelem.
KALKULATOR
Inne z tej kategorii